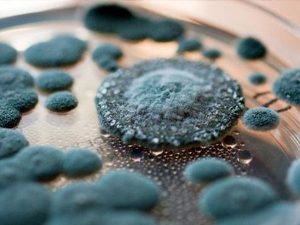
di-ung-nam-moc

Cây gối hạc trị đau nhức xương khớp
Gối Hạc (Leea rubra Blume) A. Mô Tả Cây Gối Hạc, còn được biết đến ...
Th1
Cập nhật điều trị và chăm sóc đối với trẻ cắt amiđan
Cập nhật điều trị và chăm sóc đối với trẻ cắt amiđan Viện Hàn lâm ...
Th1
Cần làm gì khi có người nhà mắc bệnh lao?
Bệnh Lao là Gì? Bệnh lao là một bệnh truyền nhiễm do khuẩn Mycobacterium tuberculosis ...
Th1
Cách giảm say sóng khi đi tàu biển
Kiến Thức Chung Về Chứng Say Sóng Khi di chuyển trên sóng biển, nhiều người ...
Th1
Các tác nhân kép của hệ thống miễn dịch được tuyển dụng giúp ngăn chặn ung thư
Ngăn Chặn Ung Thư: Bí Mật của Các Tác Nhân Kép Trong Hệ Thống Miễn ...
Th1
Các Rối Loạn Tiểu Tiện (đái dầm, tiểu đêm, tiểu són)
Đái Dầm là Gì và Ai Thường Gặp? Đái dầm là tình trạng mà trẻ ...
Th1
Các câu hỏi liên quan đến chăm sóc sức khỏe răng miệng người cao tuổi
Chăm sóc sức khỏe răng miệng người cao tuổi Răng và nướu đóng vai trò ...
Th1
Bị đau một bên tinh hoàn
Đau Một Bên Tinh Hoàn là Gì? Tinh hoàn, nơi sản xuất tinh trùng và ...
Th1
Bệnh Trào Ngược Dạ Dày Thực Quản
Bệnh Trào Ngược Dạ Dày Thực Quản Bệnh trào ngược dạ dày thực quản, hay ...
Th1
Bệnh Rối Loạn Nhân Cách Ái Kỷ
Đặc Điểm của Bệnh Rối Loạn Nhân Cách Ái Kỷ Bệnh lý Tâm Thần Hiếm ...
Th1
Bệnh lao ở người nhiễm HIV – AIDS
Theo Tổ chức Y tế Thế giới (WHO), bệnh lao hiện đang là vấn đề ...
Th1
Bệnh giun kim có triệu chứng lâm sàng gì?
Bệnh giun kim có những triệu chứng lâm sàng như thế nào? Bệnh giun kim ...
Th1
Bệnh Gai Cột Sống
Bệnh Gai Cột Sống (Spondylosis) là gì? Đặc Điểm của Bệnh: Gai cột sống, hay ...
Th1
Bệnh đau dạ dày tổng hợp
Bệnh Đau Dạ Dày Chứng Tổng Hợp: Đặc Điểm và Nguyên Nhân I. Đặc Điểm ...
Th1
Bé gái 2 tháng mắc căn bệnh hiếm gặp
Bé với ngày sinh là 19/4/2018, xuất phát từ Gia Lai, đã trải qua một ...
Th1
Bé 1 tuổi bị nhiễm virus Herpes
Dịch tễ của Virus Herpes đang ngày càng trở nên phổ biến, tác động đáng ...
Th1
25 năm chiều cao chỉ tăng 3cm, đâu là “chướng ngại vật” trong dinh dưỡng?
Dinh Dưỡng và Sức Khỏe Ở Việt Nam: Thành Tựu và Thách Thức Trong những ...
Th1
13 triệu chứng không được bỏ qua
Nhận Triệu Chứng Cần Biết Khi Cần Đến Bác Sĩ Ngay Lập Tức Ho Liên ...
Th1
Chế Độ Ăn Uống Lành Mạnh Cho Người Thiếu Máu
Chế Độ Ăn Uống Lành Mạnh Cho Người Thiếu Máu Chế độ ăn uống là ...
Th1
10 cách giảm dị ứng nấm mốc
10 Cách Giảm Dị ứng Nấm Mốc Theo dõi Số Lượng Bào tử Nấm Ngoại ...
Th1
Vitamin và khoáng chất trong trái cây
Trái cây không chỉ là nguồn cung cấp chất dinh dưỡng dồi dào mà còn ...
Th1
Trẻ nuốt phải dị vật có biểu hiện lâm sàng như thế nào?
Dị vật thường gặp mà trẻ nhỏ có thể nuốt phải bao gồm nhiều loại ...
Th1
Thuốc xịt mũi chứa Steroid
Thuốc xịt mũi chứa Steroid là gì? Thuốc xịt mũi chứa Steroid, có sẵn trên ...
Th1
Kế hoạch chăm sóc răng miệng hiệu quả
Kế Hoạch Chăm Sóc Răng Miệng Hiệu Quả Hiện nay, chăm sóc sức khỏe răng ...
Th1
Bí quyết để sống khỏe tuổi 50
6 Chiến Lược Dinh Dưỡng và Sức Khỏe Cho Người Ở Tuổi 50 Duy Trì ...
Th1
Giải độc đường tiêu hóa
Giải độc Đường Tiêu Hóa và Làm Sạch Ruột Làm Sạch Dạ Dày Bằng Nước ...
Th1
Điều trị trầy xước giác mạc
Thăm Bác Sĩ Mắt Khẩn Cấp Nếu Bạn Gặp Các Tình Huống Sau Chấn Thương ...
Th1
Bề Ngoài Chân Bị Bầm Tím và Những Nguyên Nhân Có Thể Gây Ra
Nếu chân của bạn bị bầm tím, đây có thể là dấu hiệu của những ...
Th1
Các loại khoáng chất tốt cho sức khoẻ
Các loại khoáng chất tốt cho sức khoẻ Canxi Canxi là khoáng chất chiếm tỉ ...
Th1
Bỗng nhiên thấy sưng hoặc nổi cục ở cổ và tai
Những Cục U ở Cổ và Tai: Khi Cần Lưu Ý và Tìm Sự Chăm ...
Th1
Bệnh bạch sản niêm mạc miệng điều trị thế nào?
Bệnh Bạch Sản Niêm Mạc Miệng là gì? Bệnh Bạch Sản Niêm Mạc Miệng là ...
Th1
Các số liệu thống kê chính về ung thư thận
Khác với suy thận, tình hình ung thư thận tại Việt Nam hiện vẫn còn ...
Th1
9 Điều người cao tuổi nên tránh
Khi bước vào tuổi già, mọi bộ phận trong cơ thể trở nên lão hóa ...
Th1
Sinh hoạt giao tiếp giúp kéo dài tuổi thọ
Sinh hoạt giao tiếp giúp kéo dài tuổi thọ Đối với người cao tuổi, tham ...
Th1
Bệnh tăng động giảm chú ý (ADHD)
Bệnh tăng động giảm chú ý là gì? Rối loạn tăng động giảm chú ý, ...
Th1